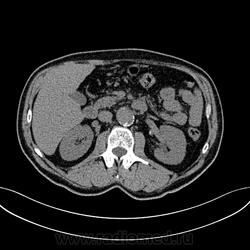

Пол пациента:
Тип патологии:
Область исследования:
Методы исследования:
- https://radiomed.ru/sites/default/files/styles/case_slider_image/public/user/17760/img-0002-00001_2.jpg?itok=N-_CFFPH
- https://radiomed.ru/sites/default/files/styles/case_slider_image/public/user/17760/img-0003-00001_2.jpg?itok=YnsDWlHV
- https://radiomed.ru/sites/default/files/styles/case_slider_image/public/user/17760/img-0004-00001_2.jpg?itok=FirpQvQg
- https://radiomed.ru/sites/default/files/styles/case_slider_image/public/user/17760/img-0005-00001_2.jpg?itok=7UHvd20L
- https://radiomed.ru/sites/default/files/styles/case_slider_image/public/user/17760/img-0006-00001_1.jpg?itok=U28kMMh9
- https://radiomed.ru/sites/default/files/styles/case_slider_image/public/user/17760/img-0007-00001_2.jpg?itok=9_fVFjP6
- https://radiomed.ru/sites/default/files/styles/case_slider_image/public/user/17760/img-0008-00001.jpg?itok=khKZqGyW
- https://radiomed.ru/sites/default/files/styles/case_slider_image/public/user/17760/img-0009-00001.jpg?itok=WdFNTlla
- https://radiomed.ru/sites/default/files/styles/case_slider_image/public/user/17760/img-0010-00001_0.jpg?itok=W_ZFxBXp
- https://radiomed.ru/sites/default/files/styles/case_slider_image/public/user/17760/img-0011-00001.jpg?itok=WDpW588f
- https://radiomed.ru/sites/default/files/styles/case_slider_image/public/user/17760/img-0012-00001_0.jpg?itok=NNBcvZ8k
- https://radiomed.ru/sites/default/files/styles/case_slider_image/public/user/17760/img-0013-00001.jpg?itok=5BAs3qeJ
- https://radiomed.ru/sites/default/files/styles/case_slider_image/public/user/17760/img-0014-00001.jpg?itok=CS-l-fPH
- https://radiomed.ru/sites/default/files/styles/case_slider_image/public/user/17760/img-0015-00001.jpg?itok=ibrr0SjB
- https://radiomed.ru/sites/default/files/styles/case_slider_image/public/user/17760/img-0016-00001.jpg?itok=tCiKEf14
- https://radiomed.ru/sites/default/files/styles/case_slider_image/public/user/17760/img-0017-00001.jpg?itok=F1uUb70-
- https://radiomed.ru/sites/default/files/styles/case_slider_image/public/user/17760/img-0018-00001.jpg?itok=Q3hg80BN
- https://radiomed.ru/sites/default/files/styles/case_slider_image/public/user/17760/img-0019-00001.jpg?itok=vbSxEg-c
ID:31674

Шикарно! Тромбированная аневризма инфраренального отдела (над бифуркацией), бифуркации и общих подвздошных артерий, синдром Лериша справа.
"Предоставляя весь смысл и совершенство в распоряжение одного только Бога, вы избавляете себя от бездны хлопот." Джон Уитборн.
Класс!
Красивое исследование. Мне понравилось так)))
И еще маленькая аневризмочка наружной подвздошной слева. Честно говоря, меня больше всего впечатлили коллатерали, благодаря которым клинически он вообще не соответствует исследованию. Конечности теплые, пульсация слабая, но как-то прослеживается...